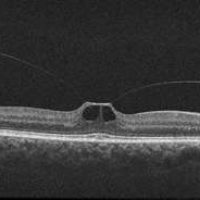
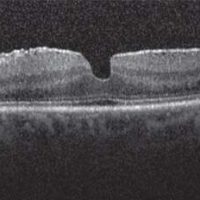

Conditions

Intraocular Lens Dislocation
SUMMARY
Cataract surgery is one of the most common and successful surgical procedures performed today. Over the past decade, the risk of severe complications has decreased with advances in surgical instruments and techniques.
CAUSES
During most cataract surgery procedures, the IOL is placed inside the capsular bag, a sack-like structure in the eye that previously contained the cloudy lens. In some situations, this extremely thin capsular bag or the fibers .
SYMPTOMS
The most common symptom of a dislocated IOL is a change in vision. The degree to which vision is affected will depend on the severity of the dislocation.
This can appear as:- Blurring
- Double vision
- Seeing the edge of the lens implant

Retained Lens Fragments
SUMMARY
As people age, the lens of the eye develops a progressive opacification or clouding called a cataract. Cataracts are a significant cause of visual loss in older adults, and often surgery is performed when the lens causes vision loss to the point where it interferes with daily activities.
CAUSES
In most cases, cataract surgery is performed without complication. However, in some eyes, the cataract cannot be removed completely and fragments of the cataract may fall into the back of the eye where they cannot be safely removed by a cataract surgeon. Even the most skilled cataract surgeons have this happen—especially when the cataract is very firm or if trauma (injury) or other conditions have damaged the attachment of the lens to the inner wall of the eye.
SYMPTOMS
Patients with retained cataract material develop symptoms that may include:
- Very blurry vision
- Eye pain from increased pressure
- Redness
- Sensitivity to light

Sickle Cell Retinopathy
SUMMARY
Sickle cell retinopathy is present in some patients with sickle cell disease. In sickle cell retinopathy, blockage of blood vessels in the retina and choroid (pronounced CORE-oid) results in abnormal blood vessel growth and thinning of the retina.
CAUSES
Sickle cell disease is:
- The most common inherited blood disorder
- Most often found among people of African, Hispanic, and Caribbean descent
- Caused by a mutation in the beta-globin gene, which decreases the ability of red blood cells to carry oxygen.
SYMPTOMS
Patients with retinal involvement of sickle cell disease often do not have any eye symptoms. However, when symptoms are present, patients describe:
- Blind spots
- Sudden onset of floaters or blurred vision
- Flashes of light
- Loss of side vision or curtains

Choroidal Detachment
SUMMARY
The choroid (pronounced “CORE-oyd”) is a spongy layer of blood vessels that lines the back wall of the eye between the retina and the sclera (or the white part of the eye). It plays an important role in delivering oxygen and nutrients to the outer half of the retina.
CAUSES
In general, choroidal detachments can be categorized as “serous” (fluid filled), or “hemorrhagic” (blood filled). Serous choroidal detachments are typically associated with a low pressure in the eye and are usually only mildly uncomfortable.
SYMPTOMS
When the choroid is detached from the back wall of the eye, patients may not feel anything at all, or may feel that the eye is achy and sore. In some cases, a choroidal detachment can cause more severe pain. Often, the vision is blurred as well, though the degree of blurring varies and often relates to other eye issues that can accompany a choroidal detachment, such as recent surgery, or high or low pressure in the eye (intraocular pressure).

Charles Bonnet Syndrome
SUMMARY
(pronounced bo NAY) is a condition that causes people with decreased vision and various eye diseases to have visual hallucinations.
CAUSES
The exact cause of visual hallucinations is not known. Most researchers believe they are due to deafferentation: a loss of signals from the eye to the brain.
SYMPTOMS
Hallucinations occur when the affected person is awake, and are usually purely visual and not associated with auditory (sound) hallucinations. A person with CBS is generally aware that images are not real, though he or she may initially be confused by them.


Choroidal Nevus
SUMMARY
A choroidal nevus (plural: nevi) is typically a darkly pigmented lesion found in the back of the eye. It is similar to a freckle or mole found on the skin and arises from the pigment-containing cells in the choroid, the layer of the eye just under the white outer wall (sclera). (Figures 1 and 2).
CAUSES
Retinal artery occlusion occurs due to blockage of the retinal artery, often by an embolus (a small piece of cholesterol that blocks blood flow) or thrombus (blood clot). The retinal artery occlusion may be transient and last for only a few seconds or minutes if the blockage breaks up and restores blood flow to the retina, or it may be permanent.
SYMPTOMS
Most commonly, a choroidal nevus does not cause any symptoms and is found on routine eye exam. However, sometimes nevi under the center of the retina (the macula) can cause blurred vision. When a nevus causes degeneration or dysfunction of the overlying RPE, fluid may accumulate under the retina or abnormal blood vessels (choroidal neovascularization) may develop and bleed or leak fluid.

Complex Retinal Detachment
SUMMARY
Proliferative vitreoretinopathy (PVR) is a condition in which retinal scar tissue, or “membranes” form; this may occur with a retinal detachment. A key risk factor for developing PVR is a giant retinal tear—a large tear that involves at least 25% of the retina. When PVR or a giant retinal tear is present, a retinal detachment is classified as “complex.”
CAUSES
The reason these membranes form is uncertain, but it is thought to be due to cells growing on the retinal surface. Passage of liquefied vitreous gel through a retinal tear or hole results in an accumulation of fluid under the retina (subretinal fluid) and progression of the retinal detachment.
SYMPTOMS
The most common symptom of macular hole is a gradual decline in the central (straight-ahead) vision of the affected eye.
This can occur as:
- Blurring
- Distortion (straight lines appearing wavy)
- A dark spot in the central vision The degree to which vision is affected will depend on the size and location of the macular hole, as well as the stage of its development.

Endophthalmitis
SUMMARY
is an infection inside the eye that can either be acute or chronic, meaning that it can develop very rapidly which is most common, or develop slowly and persist for long periods of time.
CAUSES
Acute cases of endophthalmitis are caused by gram-positive (or less frequently gram-negative) bacteria and are most often seen within 6 weeks after surgery or trauma to the eye.
SYMPTOMS
Endophthalmitis causes the white of the eye to be inflamed. There may be a white or yellow discharge on or inside the eyelid, and the cornea may show a white cloudiness. There may also be a layer of white cells (hypopyon) present within the anterior chamber of the eye between the iris and the cornea. (Figure 1) Endophthalmitis is usually a very serious problem and prompt examination by an ophthalmologist is essential to make an appropriate diagnosis and initiate treatment.

Intraocular Melanoma
SUMMARY
Malignant intraocular melanoma is the most common eye cancer in adults. The tumor affects the uveal tract, which is the middle layer of the wall of the eye.
CAUSES
During a targeted tumor examination, diagnostic testing typically includes a complete eye exam with dilation of the fundus, indirect ophthalmoscopy, tumor photography (fundus photography), tumor ultrasound, and vascular studies of the tumor (fluorescein angiography, indocyanine green angiography, spectral-domain OCT angiography (sd OCT)), along with laser studies of the macula.
SYMPTOMS
Tumor sizing Typically, ocular oncologists use 5 categories for tumor sizing: small, medium, large, extra-large, and a fifth category for borderline small tumors called atypical nevi (singular: nevus). Tumor sizing is important, as it has an impact on treatment options for the patient.

Retinitis Pigmentosa and Retinal Prosthesis
SUMMARY
(Retinal tears) is a deterioration of the retina and choroid that leads to a substantial loss in visual acuity (sharpness of vision). AMD is the leading cause of significant visual acuity loss in people over age 50 in developed countries.
CAUSES
The exact cause of AMD is unknown, but the condition develops as the eye ages. There are 2 types of AMD: non-neovascular or dry AMD; and neovascular or wet AMD. In early stages of dry AMD, the hallmark is drusen—pale yellow lesions formed beneath the retina.
SYMPTOMS
Retinitis pigmentosa symptoms can start as early as childhood, but side effects may not begin to take precedence until early adulthood. Symptoms include:
- Night blindness
- Loss of peripheral (side) vision
- Cataracts
- Loss of central vision
In some instances, the disorder progresses slowly and may be found on routine examination.

Vitreomacular Traction Syndrome
SUMMARY
The vitreous humor is a transparent, gel-like material that fills the space within the eye between the lens and the retina. The vitreous is encapsulated in a thin shell called the vitreous cortex, and the cortex in young, healthy eyes is usually sealed to the retina.
CAUSES
Age-related degeneration of the gel-like vitreous humor leads to the formation of pockets of fluid within the vitreous, causing contraction and loss of volume. The separation of the vitreous gel from the retina occurs as a result of the gel becoming liquid (liquefaction) and the continuous anterior-posterior (front-back) and tractional forces stretching on the macula over time.
SYMPTOMS
The most common symptoms experienced by patients with VMT syndrome are:
- Decreased sharpness of vision
- Photopsia, when a person sees flashes of light in the eye
- Micropsia, when objects appear smaller than their actual size
- Metamorphopsia, when vision is distorted to make a grid of straight lines appear wavy or blank

Retinal Tears
SUMMARY
(Retinal tears) is a deterioration of the retina and choroid that leads to a substantial loss in visual acuity (sharpness of vision). AMD is the leading cause of significant visual acuity loss in people over age 50 in developed countries.
CAUSES
The exact cause of AMD is unknown, but the condition develops as the eye ages. There are 2 types of AMD: non-neovascular or dry AMD; and neovascular or wet AMD. In early stages of dry AMD, the hallmark is drusen—pale yellow lesions formed beneath the retina.
SYMPTOMS
• Distortion (warping) of straight lines
• A decrease in the intensity or brightness of colors
• A gradual or sudden loss of central vision, or
• Dark, blurry areas in the center of vision.

AGE-RELATED MACULAR DEGENERATION
SUMMARY
(AMD) is a deterioration of the retina and choroid that leads to a substantial loss in visual acuity (sharpness of vision). AMD is the leading cause of significant visual acuity loss in people over age 50 in developed countries.
CAUSES
The exact cause of AMD is unknown, but the condition develops as the eye ages. There are 2 types of AMD: non-neovascular or dry AMD; and neovascular or wet AMD. In early stages of dry AMD, the hallmark is drusen—pale yellow lesions formed beneath the retina.
SYMPTOMS
• Distortion (warping) of straight lines
• A decrease in the intensity or brightness of colors
• A gradual or sudden loss of central vision, or
• Dark, blurry areas in the center of vision.

VITRECTOMY FOR FLOATERS
SUMMARY
As we get older, some of us may see “floaters” in our field of vision. In rare cases when many of these floating specks interfere with vision while driving or reading, onetreatment option is vitrectomy—surgical removal of the eye’s vitreous gel.
CAUSES
The vitreous gel is attached to the retina at birth. At some point, as a natural part of aging, the vitreous pulls free from the retina. This posterior vitreous detachment is the most common cause of floaters. Blood, inflammatory cells, or pigment cells may also collect in the vitreous cavity.
SYMPTOMS
With aging, vitreous gel may develop opacities (unclear areas) and movement, creating the sensation of bugs or dirt in the vision due to shadows cast onto the retina.

RETINAL DETACHMENT
SUMMARY
The retina lines the back wall of the eye, and is responsible for absorbing the light that enters the eye and converting it into an electrical signal that is sent to the brain via the optic nerve, allowing you to see.
CAUSES
Rhegmatogenous tears are caused by a hole or tear in the retina that allows fluid to pass through and collect underneath the retina, detaching it from its underlying blood supply. Tractional tears are caused by scar tissue that grows on the surface of the retina. Exudative retinal detachments form when fluid leaks out of blood vessels and accumulates under the retina.
SYMPTOMS
The typical symptoms of a retinal detachment include floaters, flashing lights, and a shadow or curtain in the peripheral (noncentral) vision that can be stationary (non-moving) or progress toward, and involve, the center of vision.

DIABETIC RETINOPATHY
SUMMARY
Diabetic retinopathy is a complication of diabetes that causes damage to the blood vessels of the retina— the light-sensitive tissue that lines the back part of the eye, allowing you to see fine detail..
CAUSES
The primary cause of diabetic retinopathy is diabetes—a condition in which the levels of glucose (sugar) in the blood are too high. Elevated sugar levels from diabetes can damage the small blood vessels that nourish the retina and may, in some cases, block them completely.
SYMPTOMS
Blurred or double vision, Difficulty reading, The appearance of spots— commonly called “floaters”— in your vision, A shadow across the field of vision, Eye pain or pressure, Difficulty with color perception

RETINAL ARTERY OCCLUSION
SUMMARY
Retinal artery occlusion refers to blockage of the retinal artery carrying oxygen to the nerve cells in the retina at the back of the eye. The lack of oxygen delivery to the retina may result in severe loss of vision.
CAUSES
Retinal artery occlusion occurs due to blockage of the retinal artery, often by an embolus (a small piece of cholesterol that blocks blood flow) or thrombus (blood clot). The retinal artery occlusion may be transient and last for only a few seconds or minutes if the blockage breaks up and restores blood flow to the retina, or it may be permanent.
SYMPTOMS
Retinal artery occlusion is usually associated with sudden painless loss of vision in one eye. The area of the retina affected by the blocked vessels determines the area and extent of visual loss.

MACULAR HOLE
SUMMARY
The macula is a small area in the center of the retina where light is sharply focused to produce the detailed color vision needed for tasks such as reading and driving. When a full-thickness defect develops in the macula, the condition is referred to as macular hole.
CAUSES
Macular hole commonly affects people over the age of 55 and most often occurs in women. The vast majority of cases develop spontaneously without an obvious cause. For this reason, there is currently no effective way to prevent their formation and development. If a macular hole develops in one eye, there is a 5% to 15% risk of one developing in the other eye.
SYMPTOMS
The most common symptom of macular hole is a gradual decline in the central (straight-ahead) vision of the affected eye. This can occur as:
• Blurring
• Distortion (straight lines appearing wavy)
• A dark spot in the central vision The degree to which vision is affected will depend on the size and location of the macular hole, as well as the stage of its development.

CENTRAL RETINAL VEIN OCCLUSION
SUMMARY
Central retinal vein occlusion, also known as CRVO, is a condition in which the main vein that drains blood from the retina closes off partially or completely. This can cause blurred vision and other problems with the eye.
CAUSES
Most patients with CRVO develop it in one eye. And, although diabetes and high blood pressure are risk factors for CRVO, its specific cause is still unknown. What we do know is that CRVO develops from a blood clot or reduced blood flow in the central retinal vein that drains the retina. And we have learned that a large number of conditions may increase the risk of blood clots. Some eye doctors advise testing for them. However, it is not certain how these health conditions are related to CRVO—and some of them, if diagnosed, have no agreed-to or necessary recommended treatment.
SYMPTOMS
• Many patients with CRVO have symptoms such as blurry or distorted vision due to swelling of the center part of the retina, known as the macula.
• Some patients have mild symptoms that wax and wane, called transient visual obscurations.
• Patients with severe CRVO and secondary complications such as glaucoma (a disease characterized by increased pressure in the eye) often have pain, redness, irritation and other problems.

BRANCH RETINAL VEIN OCCLUSION
SUMMARY
Retinal vein occlusions occur when there is a blockage of veins carrying blood with needed oxygen and nutrients to the nerve cells in the retina. A blockage in the retina’s main vein is referred to as a central retinal vein occlusion (CRVO), while a blockage in a smaller vein is called a branch retinal vein occlusion (BRVO).
CAUSES
Most BRVOs occur at an arteriovenous crossing—an intersection between a retinal artery and vein. These vessels share a common sheath (connective tissue), so when the artery loses flexibility, as with atherosclerosis (hardening of the arteries), the vein is compressed.
SYMPTOMS
BRVO causes a sudden, painless loss of vision. If the affected area is not in the center of the eye, BRVO can go unnoticed with no symptoms. In rare cases of an undetected vein occlusion, visual floaters from a vitreous hemorrhage (blood vessels leaking into the vitreous gel of the eye) can be the main symptom.

FLASHES & FLOATERS
SUMMARY
Posterior Vitreous Detachment (PVD AKA Flashes & Floaters) is a natural change that occurs during adulthood, when the vitreous gel that fills the eye separates from the retina, the light-sensing nerve layer at the back of the eye.
CAUSES
Over time, the vitreous gel that fills the eye becomes liquid and condenses (shrinks) due to age and normal wear and tear. Eventually it cannot fill the whole volume of the eye’s vitreous cavity (which remains the same size during adulthood) and so the gel separates from the retina, located at the very back of the eye cavity.
SYMPTOMS
• Floaters (mobile blurry shadows that obscure the vision)
• Flashes (streaks of light, usually at the side of the vision)
These symptoms usually become less intense over several weeks.

LATTICE DEGENERATION
SUMMARY
Lattice Degeneration is a condition that involves abnormal thinning of the peripheral retina, which is the tissue that lines the back wall of the eye and is critical for maintaining good vision. When lattice degeneration is present, the retina is more vulnerable to developing tears, breaks, or holes that could ultimately lead to a visually debilitating condition called a retinal detachment. For this reason, once diagnosed lattice degeneration should be closely monitored.
CAUSES
Lattice Degeneration is a condition that involves abnormal thinning of the peripheral retina, which is the tissue that lines the back wall of the eye and is critical for maintaining good vision. When lattice degeneration is present, the retina is more vulnerable to developing tears, breaks, or holes that could ultimately lead to a visually debilitating condition called a retinal detachment. For this reason, once diagnosed lattice degeneration should be closely monitored.
SYMPTOMS
• Blurred vision
• Flashing lights
• Floaters
• Curtain obscuring part of your peripheral visual field If you experience any of these, seek prompt ophthalmic care.
EPIRETINAL MEMBRANES
SUMMARY
Epiretinal Membranes (ERMs), also commonly known as cellophane maculopathy or macular puckers, are avascular (having few or no blood vessels), semitranslucent, fibrocellular membranes that form on the inner surface of the retina. They most commonly cause minimal symptoms and can be simply observed, but in some cases they can result in painless loss of vision and metamorphopsia (visual distortion).
CAUSES
The most common cause of macular pucker is an age-related condition called posterior vitreous detachment (PVD), where the vitreous gel that fills the eye separates from the retina, causing micro-tears and symptoms of floaters and flashes.
SYMPTOMS
Most patients with ERMs have no symptoms; their ERMs are found incidentally on dilated retinal exam or on retinal imaging such as with ocular coherence tomography (OCT).

CENTRAL SEROUS CHORIORETINOPATHY
SUMMARY
Central Serous Chorioretinopathy Central serous chorioretinopathy, commonly referred to as CSC, is a condition in which fluid accumulates under the retina, causing a serous (fluid-filled) detachment and vision loss. CSC most often occurs in young and middle-aged adults. For unknown reasons, men develop this condition more commonly than women. Vision loss is usually temporary but sometimes can become chronic or recur.
CAUSES
The causes of CSC are not fully understood. It is thought that any systemic exposure to a corticosteroid drug can bring about or worsen CSC. Corticosteroids are found in allergy nose sprays and anti-inflammatory skin creams available over the counter, and are often prescribed to treat a variety of medical conditions.
SYMPTOMS
Blurry central vision, which often occurs in one eye, is the most common symptom that patients experience; however, careful examination often reveals some involvement in the other eye as well.

OCULAR HISTOPLASMOSIS SYNDROME
SUMMARY
Presumed Ocular Histoplasmosis Syndrome (POHS) causes atrophy (wasting) around the optic nerve and multiple scars, called histo spots, in the choroid. These symptoms are accompanied by new blood vessel growth (neovascularization) that starts adjacent to a histo spot.
CAUSES
Histoplasmosis is a disease caused by Histoplasma capsulatum (H. capsulatum), a soil fungus prevalent in certain parts of the American continent, in particular the Ohio and Mississippi River valleys.
SYMPTOMS
Symptoms include painless progressive blurring of central vision and wavy vision (metamorphosia), which can be sudden or develop slowly.












